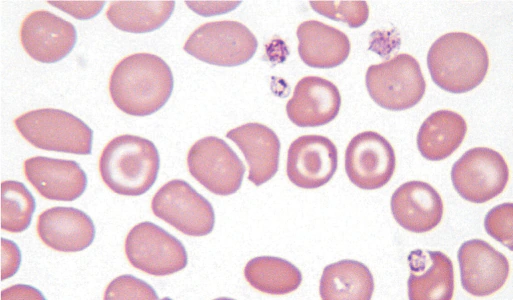
<p>what is a codocyte (target cell)?</p>
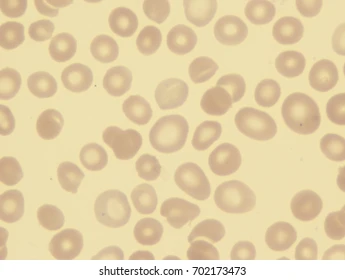
<p>what is a leptocyte?</p>
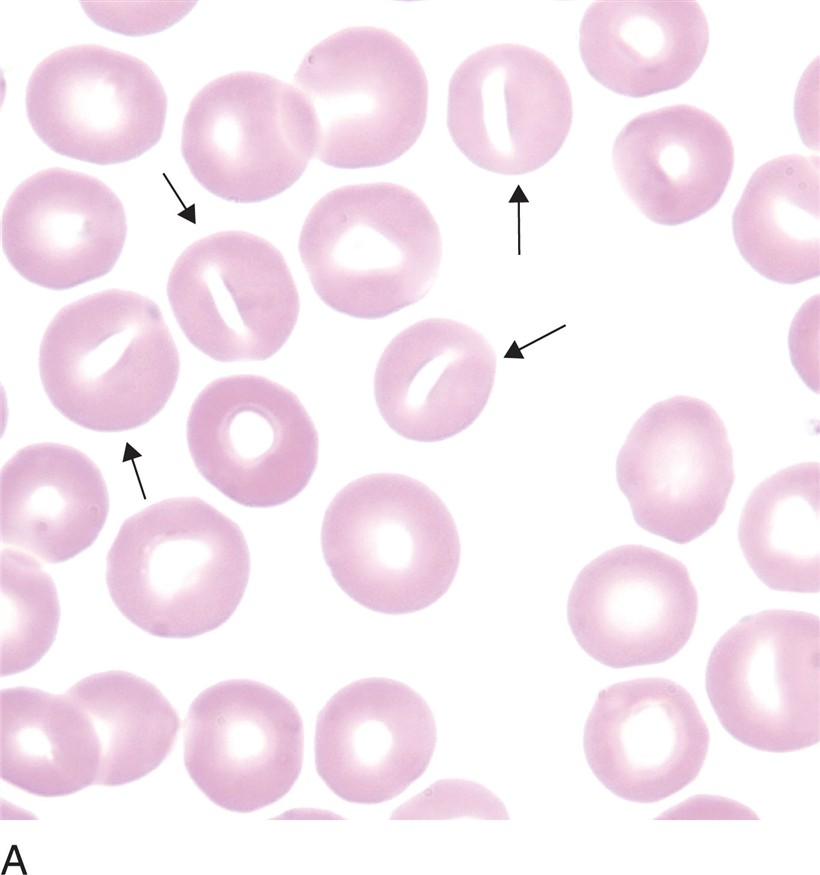
<p>what is a stomatocyte (mouth cell)?</p>
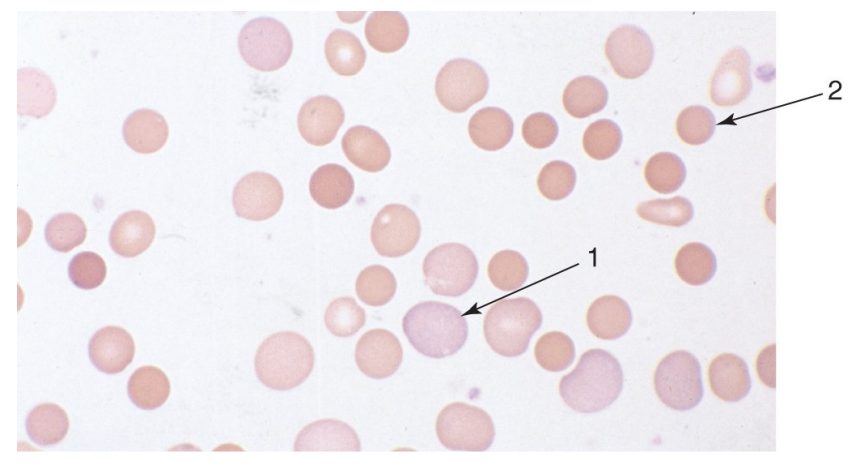
<p>what are polychromatophilic RBCs (reticulocytes)?</p>
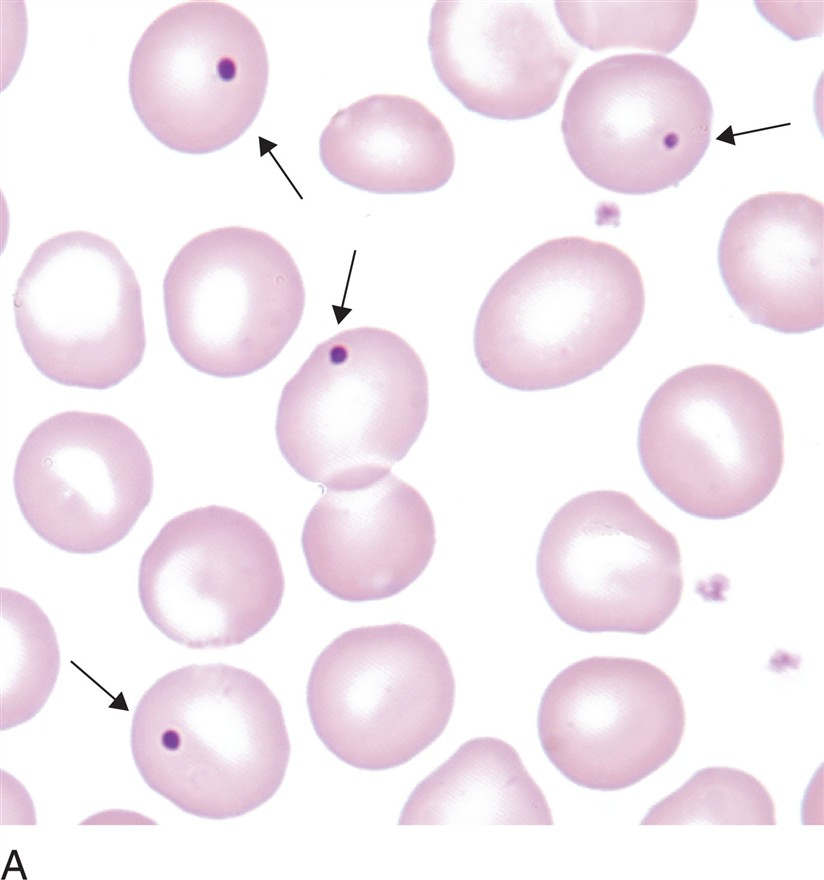
<p>what are howell-jolly bodies? (RBC inclusions)</p>
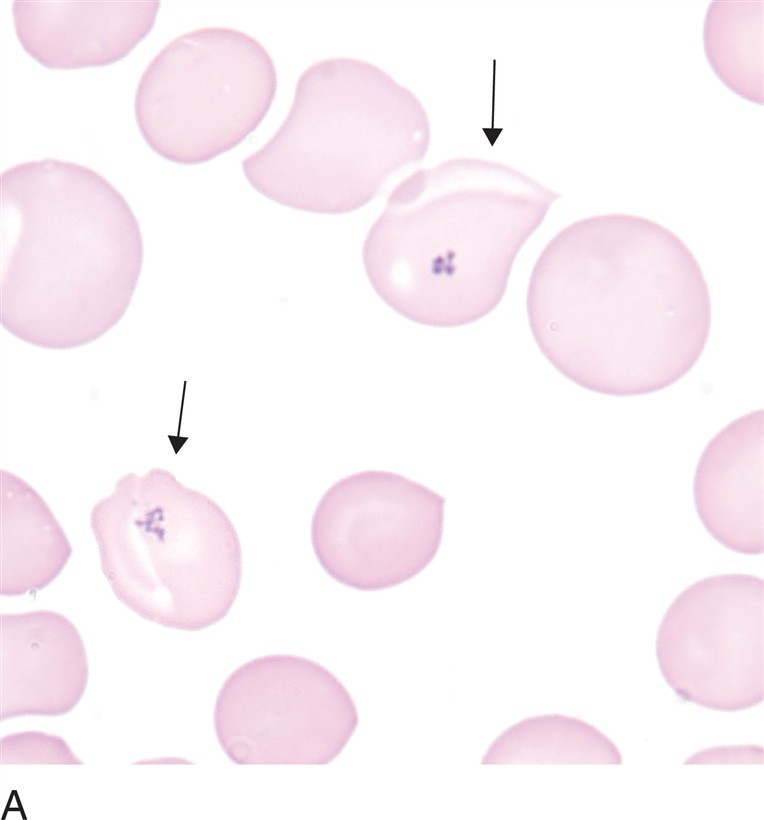
<p>what are pappenheimer bodies? (RBC inclusions)</p>
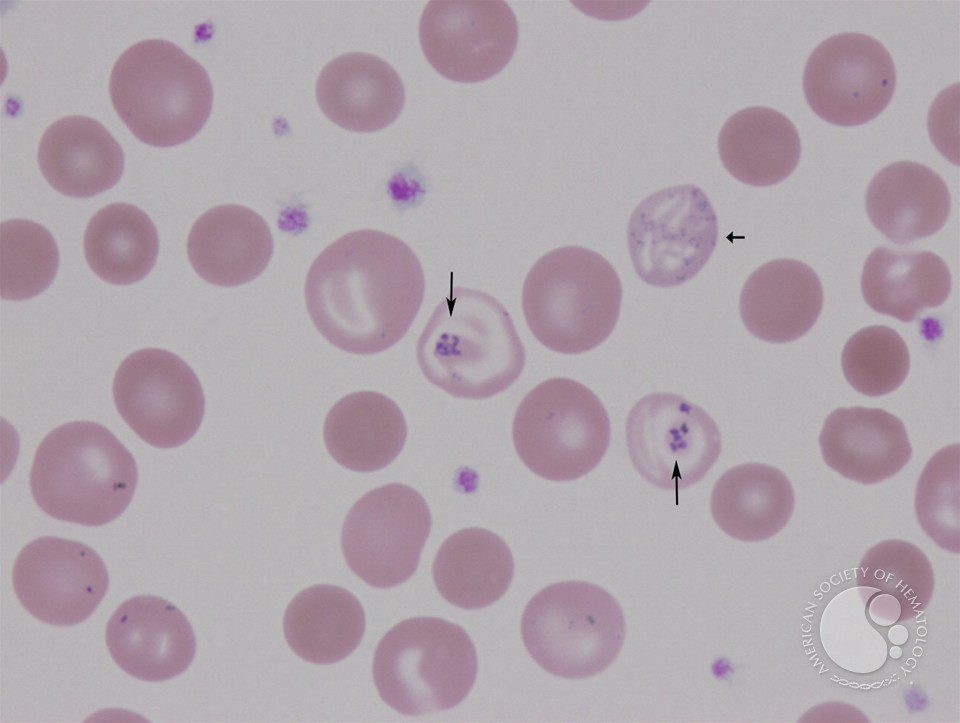
<p>what are siderocytes? (RBC inclusions)</p>
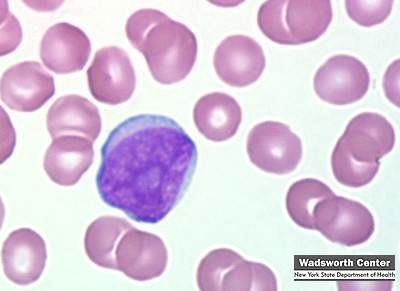
<p>what is a myeloblast?</p>
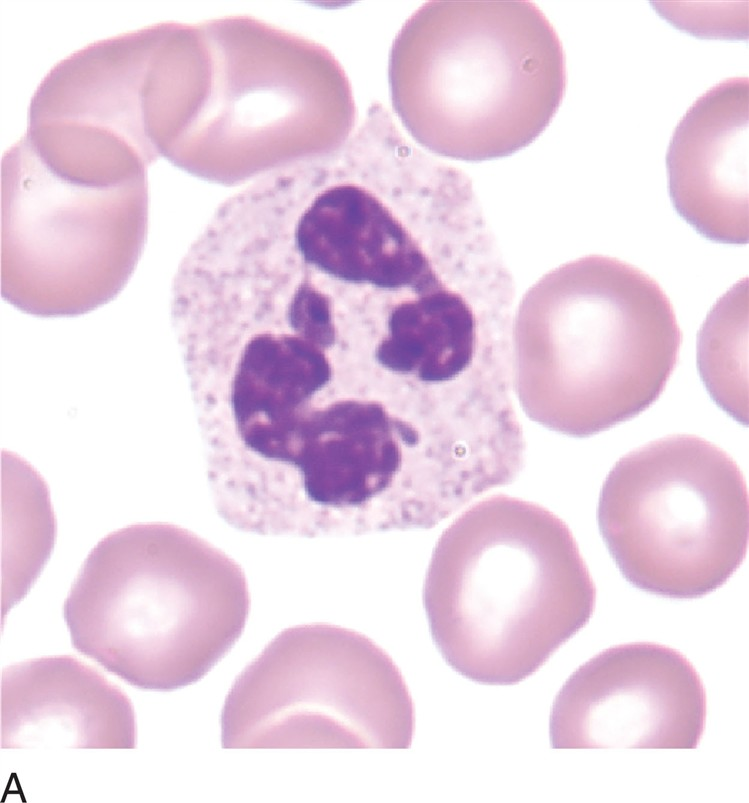
<p>what is a segmented neutrophil?</p>
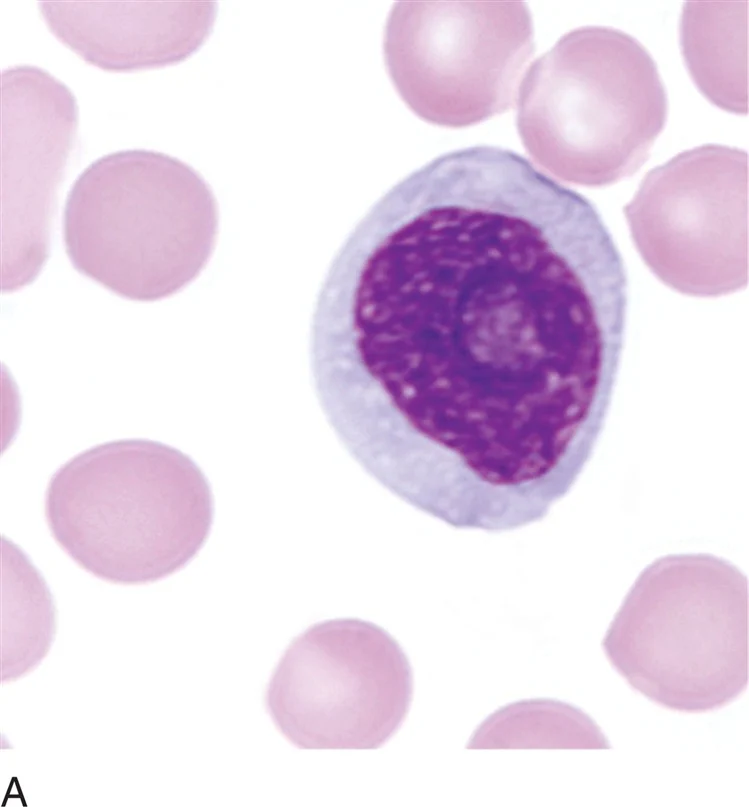
<p>what is a prolymphocyte?</p>
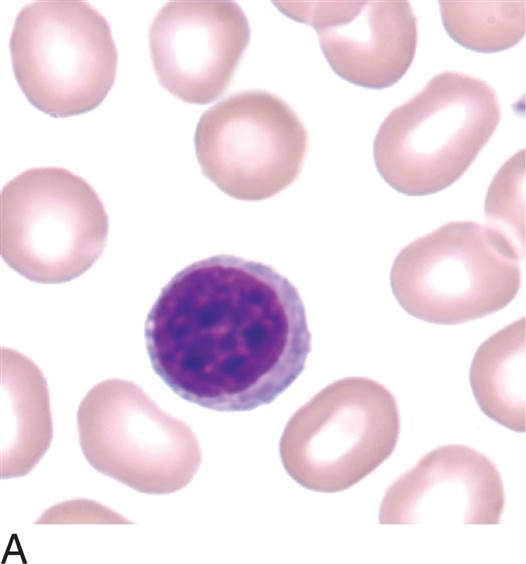
<p>what is a small lymphocyte?</p>
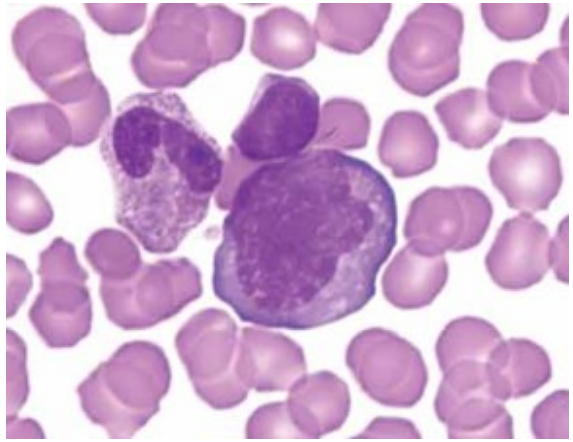
<p>what is an immunoblast?</p>
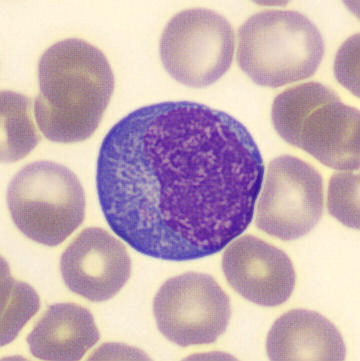
<p>what is a plasmacytoid lymphocyte?</p>
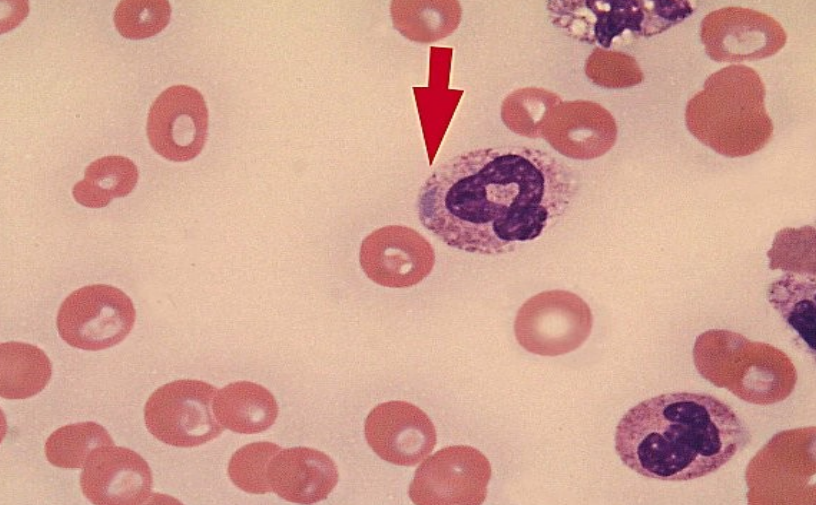
<p>what are dohle bodies?</p>
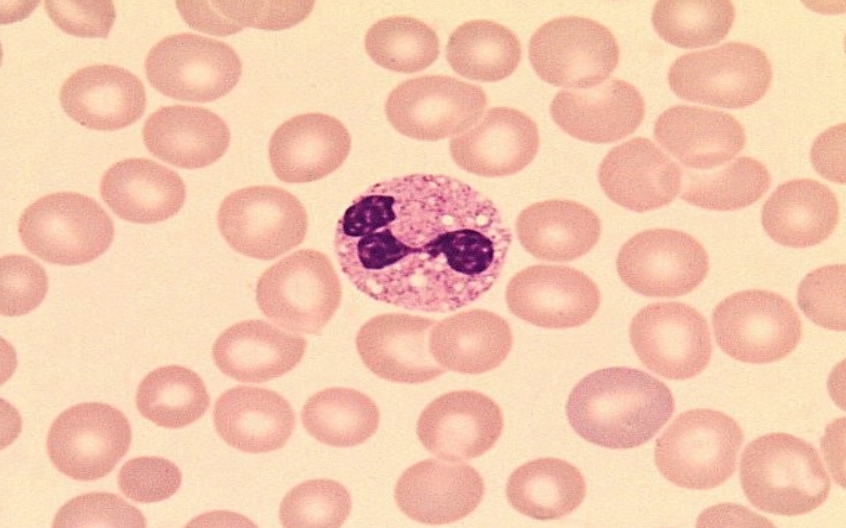
<p>what are cytoplasmic vacuoles?</p>
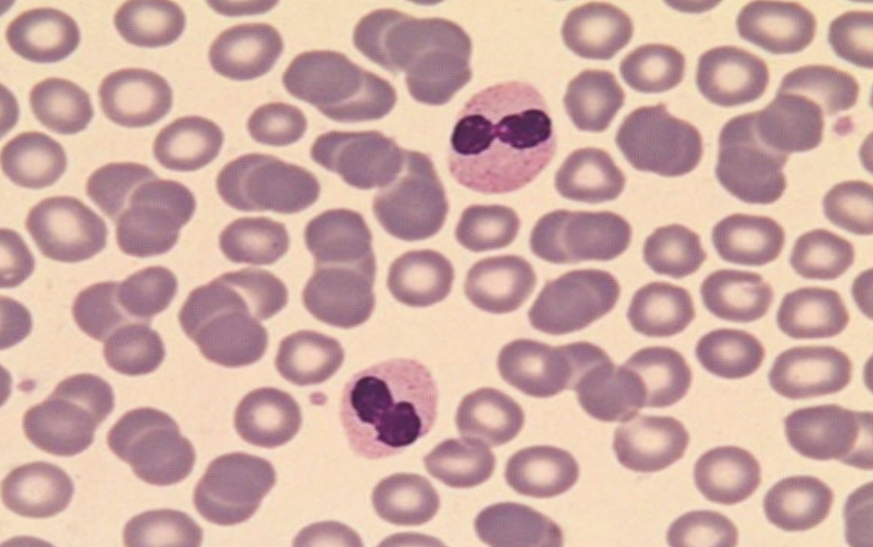
<p>what are the pelger-heut anomaly characteristics?</p>
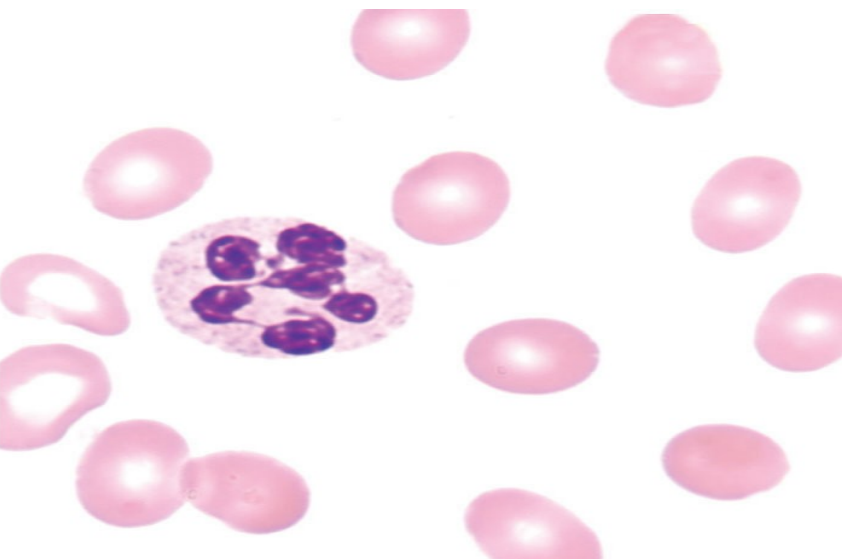
<p>what is hypersegmentation?</p>
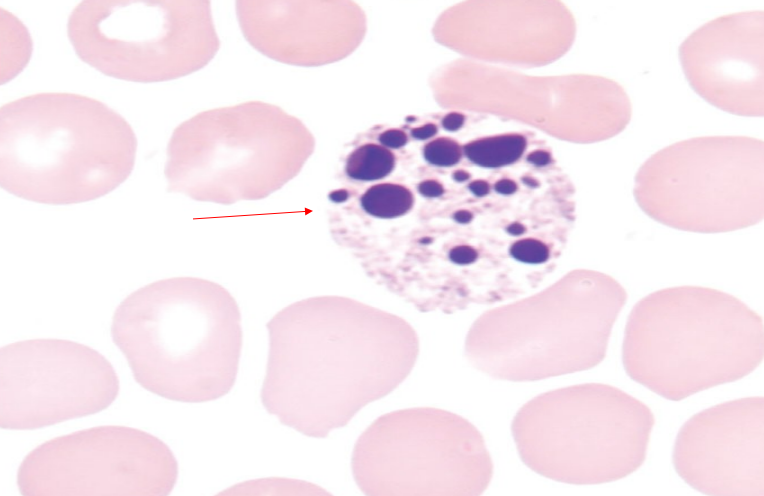
<p>what is a pyknotic nucleus?</p>
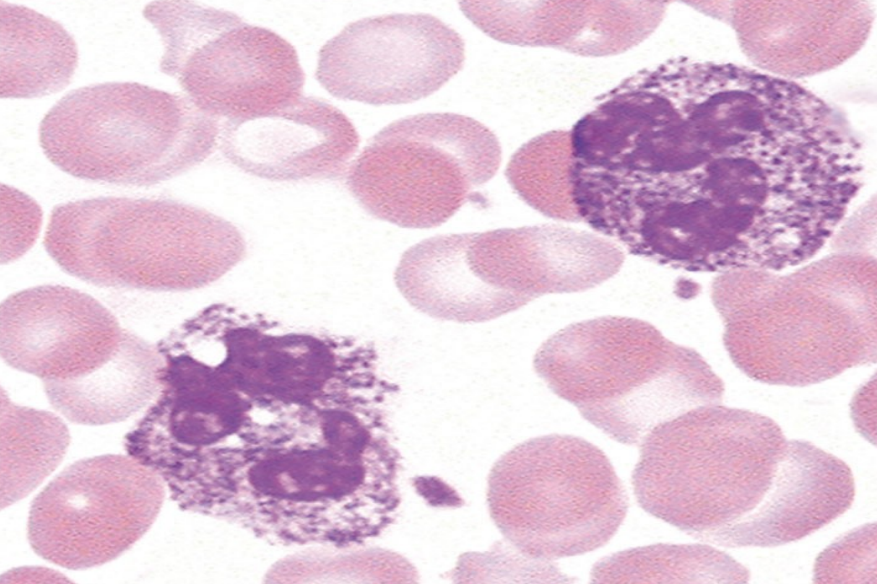
<p>what are the characteristics of the alder-reilly anomaly?</p>
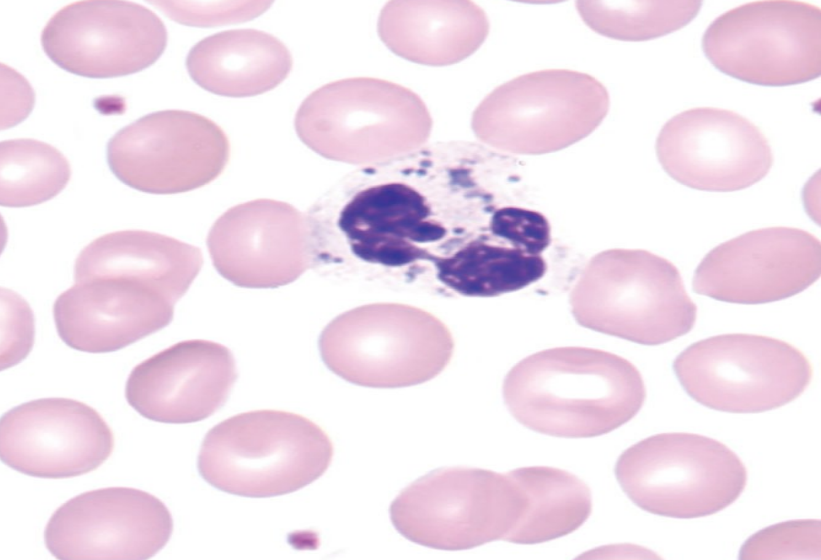
<p>what are the characteristics of chediak-higashi syndrome?</p>
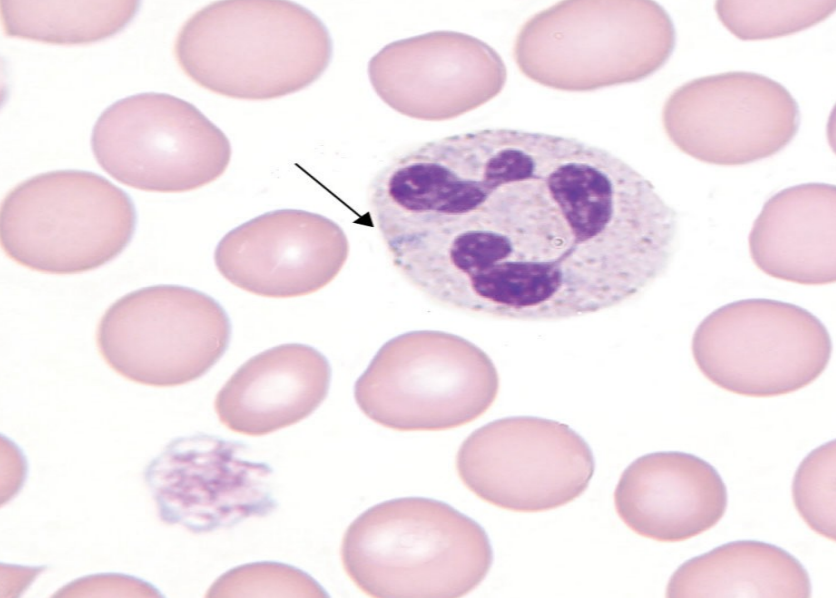
<p>what are the characteristics of may-hegglin?</p>
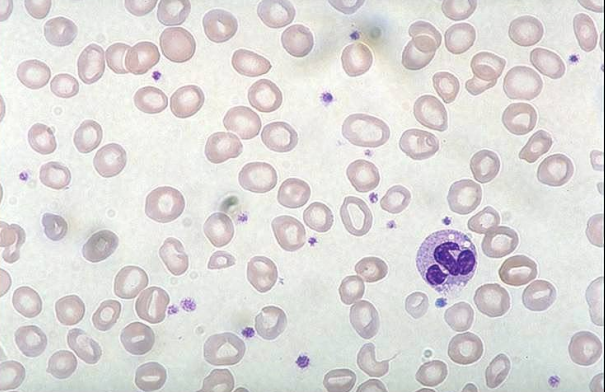
<p>what anemia is this?</p>
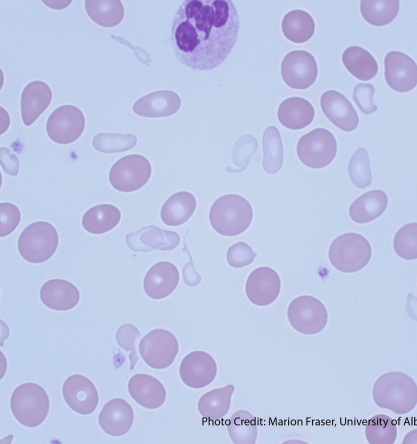
<p>what anemia is this?</p>
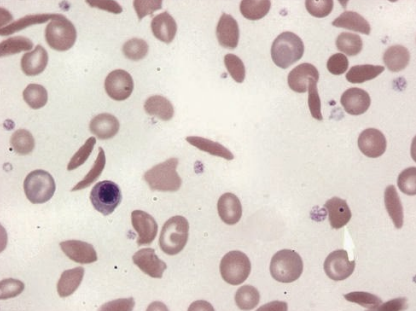
<p>what anemia is this? what is the inclusion present?</p>
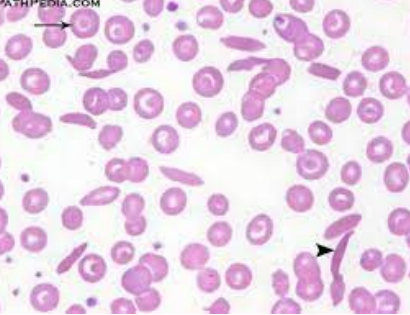
<p>what hemoglobinopathy is this?</p>
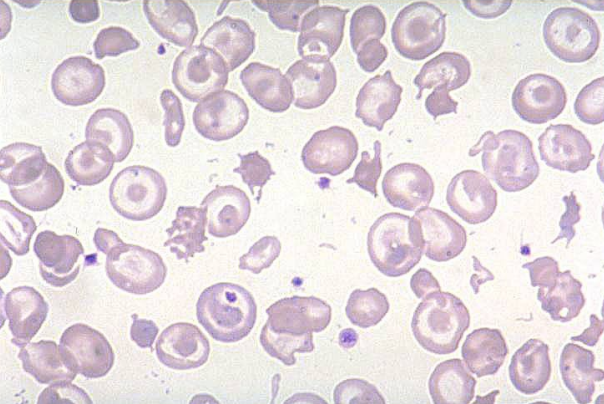
<p>what hemoglobinopathy is this?</p>
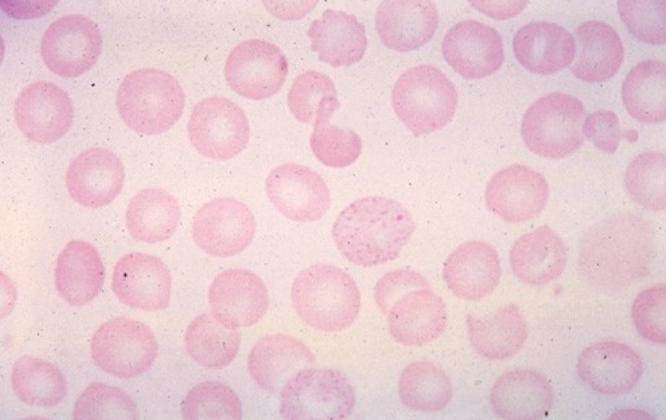
<p>what hemoglobinopathy is this? what inclusion is present?</p>
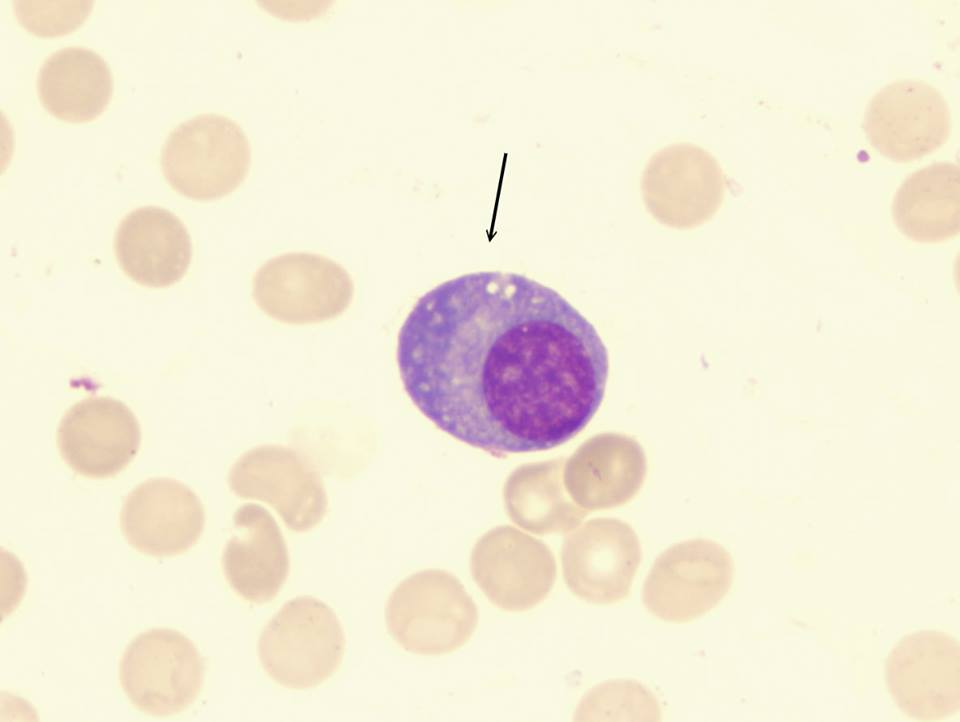
<p>what cell is this?</p>
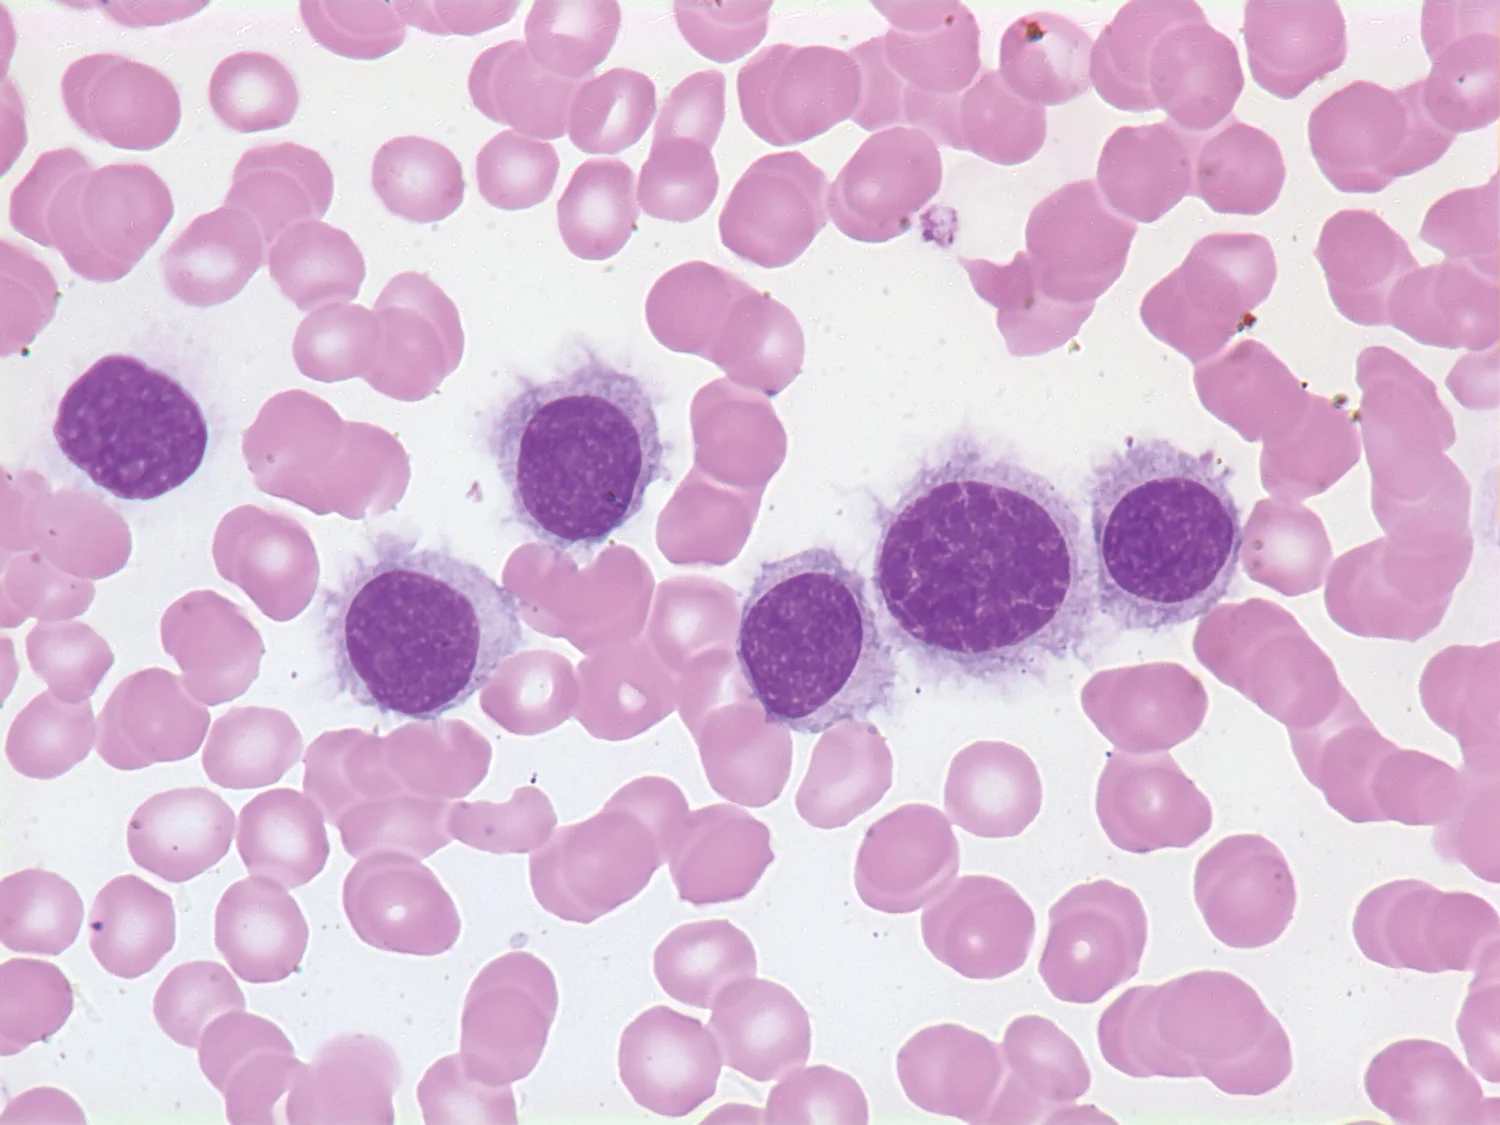
<p>what cell is this?</p>
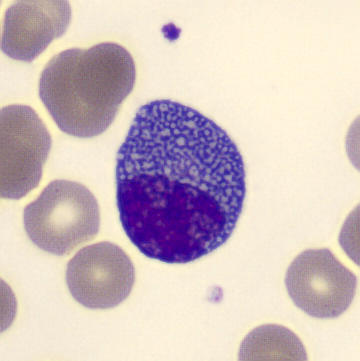
<p>what cell is this?</p>

CLS 291 and 292 RBC and WBC MORPHOLOGY
1/86
Earn XP
Description and Tags
.
Name | Mastery | Learn | Test | Matching | Spaced | Call with Kai |
|---|
No analytics yet
Send a link to your students to track their progress
87 Terms
describe a normal erythrocyte
- a discocyte due to biconcave shape and is 7-8 μm with an MCV of 80 - 100 fL
- area of central pallor (indent) is surrounded by a rim of pink-staining hemoglobin and roughly 1/3rd of the diameter of the cell
what is the general trend for when cells mature?
as cells mature, they go from a larger immature cell to a smaller mature cell (doesn’t apply to thrombocytes)
what is anisocytosis? how are the RBCs evaluated microscopically to confirm anisocytosis?
variation in red cell size (macrocytes, microcytes) with an RDW of >14.5% (suggests diff sizes of RBCs are present) and MCV is either less than 80 fL or more than 100 fL
- RBCs are compared with the nucleus of a normal small lymphocyte and normocytic RBCs are about the same size as the nucleus of small lymphocyte
what are microcytes (anisocytosis)?
RBCs have the diameter of <7.0 μm, MCV < 80fL, and usually hypochromic but can be normochromic
- if in the shape of spheres → microspherocytes and can appear hyperchromic
what are macrocytes (anisocytosis)?
RBCs have a diameter of >8.0 μm and a MCV of >100 fL with an adequate amount of Hb (normal MCHC 32-36% and normal [28 - 34 pg] to higher MCH)
- younger RBCs are larger than mature RBCs for 1 day then the spleen grooms them to normal size (reticulocyte count is up, the MCV can be up)
what is poikilocytosis?
used to describe nonspecific variation in shape of RBCs
- some shapes and sizes are characteristic of specific underlying hematological disorder or malignancies
- some morphology may be artifactual like from poorly made or improperly stained smears

what is an acanthocyte (spur cell)?
small spherical cells that does not have a central pallor with irregular thornlike projections (projections may have small bulklike tips)
- RBC membranes have altered lipid content due to increased free cholesterol accumulation leading to decreased fluidity in RBC membrane
- diseases → abetalipoproteinemia, alcoholic liver disease, disorders of lipid metabolism, post splenectomy, fat malabsorption, retinitis pigmentosa
what is a codocyte (target cell)?
thin, bell shaped cells with an increased surface area-to-volume ratio
- will look like a target cell with a bull’s eye in the center on a blood smear (bulls' eye is surrounded by an achromic zone and a thin outer ring of pink-staining Hb)
- can appear as artifacts when a wet smear is not dried correctly or made in high humidity environment
- diseases → hemoglobinopathies, thalassemias, obstructive liver disease, splenectomy, renal disease, iron deficiency anemia

what is a dacryocyte (tear drop cell)?
RBCs that are elongated on one end to form a teardrop
- formed when the RBCs containing inclusions traverse the spleen (remember spleen pits and culls) → area with the inclusion has difficulty passing through the splenic filter and the cell becomes stressed and cannot return to its normal shape
- diseases → myelophthisic anemias, primary myelofibrosis, thalassemia

what is a drepanocyte (sickle cell)?
elongated, crescent-shaped RBC with pointed ends… some forms have more rounded ends with a flat side (reversible)
- Hb is abnormal and polymerizes into rods in decreased O2 tension or decreased pH conditions → first forms a holly leaf shape and then as Hb polymerization continues, it changes to a sickle cell
- has increased mechanical fragility
- diseases → sickle cell disorders

what is an echinocyte (burr cell)?
smaller than normal RBCs (7-8 mcM) with regular, spinelike projections
- reversible meaning it can revert back to a discocyte
- can become a spherocyte due to the removal of the membrane spines in spleen
- common artifact in blood smears due to a “glass effect” when making smear and can appear within several days of storing blood at 4C
- true echinocytes thought to be related to an increase in the area of the outer leaflet of the RBC membrane
- diseases → liver disease, uremia, pyruvate kinase deficiency, peptic ulcers, cancer of stomach, heparin therapy

what is an elliptocyte (pencil or cigar cells)?
varies from elongated oval shapes (ovalocytes) to elongated rodlike cells with a central area of biconcavity with Hb concentration at both ends
- formed after cell leave the bone marrow (reticulocytes and young erythrocytes are normal in shape)
- mechanism of formation assumed to involve alterations in RBC membrane skeleton
- the predominant shape in hereditary elliptocytosis
- diseases → hereditary elliptocytosis, iron deficiency anemia, thalassemia, anemia associated with leukemia

what is a keratocyte (helmet cell)?
has a concavity on one side and two hornlike protrusions on either end and produced by impalement on a fibrin strand
- two halves of the RBC hang over the strand, membranes touch and fuse, produces a vacuole-like inclusion on one side called a blister cell, and the vacuole bursts which leaves a notch with two spicules
-diseases → microangiopathic hemolytic anemias, glomerulonephritis, Heinz-body hemolytic anemia, heart-valve hemolysis

what is a knizocyte?
cells with more than two concavities (double stoma)
- most have a dark-staining band across the center with pale area on either side and surrounded by a rim of pink-staining Hb
- mechanism of formation is unknown
what is a leptocyte?
thin, flat cells with normal or larger than normal diameter
- MCV is usually decreased with an increased surface-to-volume ratio (due to decreased Hb content or increased surface area)
- usually cup shaped like a stomatocyte (cup has little depth)
- target cells can be formed from leptocytes on dried blood smears
- diseases → thalassemia, iron deficiency anemia, hemoglobinopathies, liver disease

what is a schistocyte (RBC fragment)?
caused by mechanical damage to cells and has a variety of shapes (triangular, comma shaped, helmet shaped, and usually microcytic)
- normal deformability but reduced survival
- fragments can assume a spherical shape… may hemolyze or be removed by spleen
- diseases → microangiopathic hemolytic anemias, DIC, severe burns, uremia, heart-valve hemolysis

what is a spherocyte?
RBCs that have lost their biconcavity due to decreased surface-to-volume ratio… densely stained sphere lacking central pallor
- often appear microcytic but MCV is usually normal
- the only RBC that can be called hyperchromic because of increased MCHC
- diseases → hereditary spherocytosis, severe burns, transfusion with ABO incompatibility, Heinz-body hemolytic anemias
what is a stomatocyte (mouth cell)?
RBCs that have a slit-like area of pallor and is a reversible shape
- wet-prep appears as cup-shaped discs
- thought to be the result of an increase in the lipid content or area of the inner leaflet
- can appear as artifact on smear which means care should be taken when calling stomatocytes
- diseases → hereditary stomatocytosis, lead intoxication, alcoholic cirrhosis, spherocytosis
what is hyperchromic?
contains more Hb than normal and the only RBC that should be hyperchromic is the spherocyte meaning the term should be used sparingly (if ever)

what is hypochromia?
RBCs contain less Hb than normal and MCHC will be decreased with a central pallor >1/3 of the diameter of the RBC… result of decreased or impaired Hb synthesis
what are polychromatophilic RBCs (reticulocytes)?
usually larger than normal RBCs and has a bluish tinge on a Romanowsky stain due to residual RNA in the cytoplasm (must use a supravital stain to definitively identify reticulocytes)
- larger numbers are associated with an erythroid hyperplastic marrow due to decreased RBC survival and hemorrhage

what is basophilic stippling? (RBC inclusions)
bluish-black granular (vary in size and distribution) inclusions that is distributed across the entire cell area and composed of aggregated ribosomes
- believed that stippling is produced during slide prep as artifact (not seen in living cells)
- can occur when slide is dried slowly or stained rapidly
- seen in lead poisoning, anemia associated with abnormal Hb synthesis, thalassemia
looks like blueberry muffin

what are cabot rings? (RBC inclusions)
reddish violet RBC inclusions in the formation of a figure 8 or oval ring
- thought to be remnants of spindle fibers from mitosis
- seen in severe anemias and dyserthropoiesis
what are howell-jolly bodies? (RBC inclusions)
dark purple or violet spherical granules and are nuclear (DNA) fragments
- usually occur singly in RBCs, rarely more than two per cell
- associated with nuclear maturation abnormalities
- seen in post-splenectomy, megaloblastic anemias, some hemolytic anemias, functional asplenia, severe anemia

what are heinz bodies? (RBC inclusions)
appears as 2-3 μm round masses lying just under or attached to the cell membrane when stained with supravital stain and composed of aggregated denatured Hb
- do not stain with romanowsky stain
- seen in G6PD deficiency, unstable Hb disorders, oxidizing drugs or toxins, post-splenectomy
what are pappenheimer bodies? (RBC inclusions)
damaged secondary lysosomes and mitochondria variable in their composition of protein and iron and appears as clusters of small granules in RBCs and erythroblasts
- romanowsky stains protein matrix of granules and prussian blue stains iron portion
- only occurs in pathological states (sideroblastic anemia, thalassemia)

what are sideroblasts? (RBC inclusions)
nucleated RBCs that contain stainable iron granules
what are siderocytes? (RBC inclusions)
non-nucleated mature RBCs that contain stainable iron granules
what stain stains siderocytes and sideroblasts?
stained by prussian blue and stains the iron that aggregates blue
- 20-60% all erythroblasts in BM contain iron (increased or decreased in pathologic states)
- reticulocytes and RBCs don’t normally contain stainable iron aggregates unless patient is splenectomized
what are the CBC variations in newborns?
- WBC count is higher (25.0 × 103/mcL), granulocytes increase but drops within 72 hours
- immature WBCs in circulation for 2 weeks
- RBCs are macrocytic (large)
- reticulocyte count is 2-6%
- at birth, highest RBC, Hb, Hct values then gradually decreases (MCV neonates 108 fL, decreased to 77 fL between 6 months to 2 years, MCHC remains constant)
what are the CBC variations in children?
- lymphs are predominant cell until ages 4 or 5
- 4-5 years, there is an equal number of lymphocytes and granulocytes
- 8 years old, same WBC subsets as adults (1.8 - 7.0 × 103/mcL)
what are the CBC variations in the elderly?
- BM cellularity decreases with age
- anemia becomes more prevalent due to iron deficiency, vitamin B12 deficiency, anemia of chronic inflammation, kidney disease, and decreases testosterone levels
- malignancies occur at higher incidence
what are the CBC variations in African Americans?
- lower Hb, Hct, MCV than caucasians
- 30% prevalence of alpha-thalassemia
- WBCs lower, particularly granulocytes but lymphocytes are higher
what is a myeloblast?
larger cell (14-30 uM) with a high N:C ratio
- will have more nucleoli (white spots in the nucleus) with ~2-5
- nucleus is HUGE → round or oval with fine, delicate chromatin (looks soft)
- cytoplasm will usually LACK GRANULES (agranular) but can contain up to 20

what is a promyelocyte?
15-21 uM in size with a high N:C ratio
- will most likely have nucleoli with ~1-3 but are less visible
- nucleus is round to oval but chromatin is slightly more condensed
- cytoplasm will HAVE GRANULES that are basophilic and reddish-purple (primary) of more than 20

what is a myelocyte?
12-18 uM with a N:C ratio of 2:1
- has NO NUCLEOLI
- nucleus is smaller due to the condensing of chromatin but is still round, oval, and slightly flattened on one side → could be eccentric (slightly off center)
- may see golgi right next to the nucleus (slightly clear)
- cytoplasm contains more granules of primary (azurophilic [reddish purple]) and secondary (pink or lilac)
if you can call the background cytoplasm pink, it should at least be a myelocyte

what is a metamyelocyte?
10-18 uM
- nucleus is INDENTED AND KIDNEY BEAN SHAPED but the indentation has to be LESS than 50% of a hypothetical round nucleus and chromatin is moderately clumped (if indentation is less than halfway across nucleus)
- cytoplasm has a NEUTRAL PINK COLOR

what is a banded neutrophil?
9-15 uM
- nucleus has INDENTATION MORE THAN HALF OF THE HYPOTHETICAL ROUND NUCLEUS (meaning if you pushed it in more, it should be less than halfway) and chromatin is starting to get more condensed
- cytoplasm is PINK TO TAN and will have all the granules present
what is a segmented neutrophil?
9-15 uM
- nucleus will have segments of two or more lobes but they are all connected by a thin nuclear filament and is more condensed
- cytoplasm is PINK OR TAN TO CLEAR COLOR with many secondary, tertiary granules, and secretory vesicles

what is an eosinophilic myelocyte?
12-18 uM
- nucleus is round to oval and could have one flattened side with NO VISIBLE NUCLEOLI and chromatin is more coarse and condensed
- cytoplasm is colorless to pink with a variable number of PALE ORANGE TO DARK ORANGE SECONDARY GRANULES that are larger than neutrophil granules

what is an eosinophilic metamyelocyte?
10-15 uM
- nucleus is INDENTED WITH A KIDNEY BEAN SHAPE with indentation that is LESS THAN 50% with coarse, clumped chromatin
- cytoplasm is COLORLESS AND CREAM COLORED with many PALE ORANGE TO DARK ORANGE secondary granules

what is an eosinophilic band?
10-15 um
- nucleus is constricted (narrow or pinched in one area) with no threadlike filament and INDENTATION IS MORE THAN 50% OF HYPOTHETICAL NUCLEUS and chromatin has to be visible in constriction
- cytoplasm is colorless, cream colored with ABUNDANT PALE TO DARK ORANGE SECONDARY GRANULES

what is a basophil?
10-15
- nucleus is segmented
- key distinction is cytoplasm has MANY DARK PURPLE GRANULES that messes with the visualization of the background of cytoplasm and nucleus

what is a monoblast?
12-20 uM
- nucleus is ovoid (egg-shaped) or round and can be FOLDED or INDENTED with PALE BLUE-PURPLE, finely dispersed lacy chromatin and SEVERAL NUCLEOLI
- cytoplasm has ABUNDANT AGRANULAR BLUE-GRAY CYTOPLASM

what is a promonocyte?
12-20 uM
- nucleus is IRREGULAR and INDENTED with fine chromatin network and will be COARSER than monoblast and could have some nucleoli
- cytoplasm is ABUNDANT with BLUE-GRAY color and could have AZUROPHILIC GRANULES

what is a monocyte?
12-20 uM
- nucleus is HORSESHOE or BEAN SHAPED with NUMEROUS FOLDS (brainlike convolutions) with LOOSER and LINEAR chromatin with a lacy pattern
- cytoplasm is BLUE-GRAY with an EVENLY DISPERSE with FINE, DUSTLIKE MEMBRANE BOUND GRANULES (GROUND GLASS) with vacuoles

what is a macrophage?
15-80 uM (monocyte that has gone from PB to tissues)
- nucleus is ROUND with a NETLIKE (reticular) appearance with NUCLEOLI
- cytoplasm is BLUE-GRAY with IRREGULAR EDGES and MANY VACUOLES

what is a lymphoblast?
10-18 uM with high N:C ratio (will barely see any cytoplasm)
- nucleus is ROUND to OVAL with ONE or TWO WELL DEFINED PALE BLUE NUCLEOLI with chromatin that is lacy, fine, and more smudged compared to myeloblasts
- cytoplasm is AGRANULAR and LESS BASOPHILIC than other WBC blasts
what is a prolymphocyte?
9-18 uM with a lower N:C ratio (will see more cytoplasm compared to lymphoblast)
- nucleus is ROUND or INDENTED with usually ONE SINGLE, PROMINENT LARGE NUCLEOLUS (0-1) with chromatin that is slightly more clumped and finer than a lymphocyte
- cytoplasm is LIGHT BLUE and GRANULAR
what is a small lymphocyte?
7-10 uM
- nucleus is about the SAME SIZE AS RBC and will OCCUPY ABOUT 90% OF CELL with barely visible nucleoli with chromatin that is DEEPLY CONDENSED and STAINS DEEP PURLPLE
- cytoplasm will be SCANT (very little cytoplasm) will have SMALL RIM and is SKY BLUE with a few azurophilic granules and vacuoles could be present (vacuoles are not a distinguishable factor between monocytes and lymphocyte)
will have hand mirror shape due to motility of lymph

what is a large lymphocyte?
11-16 uM
- nucleus is SLIGHTLY LARGER with MORE DISPERSED CHROMATIN
- cytoplasm is LIGHTER BLUE with peripheral basophilia (increased # of basophils in PB) and if azurophilic granules are present in prominent → large granular lymphocyte

what is a large granular lymphocyte?
medium to large
- nucleus is ROUND or INDENTED
- cytoplasm is ABUNDANTLY PALE BLUE with COARSE PINK GRANULES and will have LARGE GRANULES but a significant portion is AGRANULAR

what is a reactive lymphocyte?
increase in size of 16-30 uM with decreased N:C ratio
- COULD see nucleoli
- nucleus is ROUND, ELONGATED, STRETCHED, or IRREGULAR and chromatin is dispersed
- cytoplasm has an INCREASE in DIFFUSE or LOCALIZED BASOPHILIA and could have AZUROPHILIC GRANULES and/or VACOLES → could be indented by surrounding RBCs which gives a cell a SCALLOPED EDGE
what is an immunoblast?
NEXT STAGE IN BLAST TRANSFORMATION IN AN ACTIVATED LYMPHOCYTE → 12-25 uM
- nucleus is LARGE, CENTRALLY PLACED with PROMINENT NUCLEOLI and FINE CHROMAITIN which STAINS PURPLE-BLUE
- cytoplasm is ABUDANT WITH AN INTENSE BLUE COLOR
can be T or B lymphocyte
what is a plasmacytoid lymphocyte?
15-20 uM
- nucleus is either CENTRAL or SLIGHT ECCENTRIC and could have a SINGLE VISIBLE NUCLEOLUS with less clumped chromatin than a plasma cells
- cytoplasm is DEEPLY BASOPHILIC

what is a plasma cell?
14-20 uM and is round or slightly oval
- nucleus is ECCENTRICALLY PLACED with COARSE BLOCKLIKE RADIAL MASSES of CHROMATIN with NO NUCLEOLI (cartwheel or spoke wheel arrangement)
- golgi apparatus is obvious
- cytoplasm is DEEPLY BASOPHILIC with a HIGH RNA CONTENT and a well developed RER and will ENLARGE due to production of large amounts of Ig and membrane slg is usually absent → could have azurophilic granules or rodlike crystal inclusions

what is a megakaryoblast?
6-25 uM
- nucleus is ROUND with VISIBLE NUCLEOLI
- cytoplasm is SCANT (little cytoplasm), BASOPHILIC and has NO VISIBLE GRANULES

what is a promegakaryocyte?
14-30 uM
- nucleus is either INDENTED or BILOBED
- cytoplasm is INCREASED and PRIMARILY BASOPHILIC with a FEW VISIBLE AZUROPHILIC CYTOPLASMIC GRANULES
- beginning of demarcation membranes that is visible with electron microscopy

what is granular megakaryocyte?
25-50 uM
- nucleus is LARGE and MULTILOBED with NO VISIBLE NUCLEOLI
- cytoplasm is ABUNDANTLY ACIDOPHILIC with NUMEROUS CYTOPLASMIC GRANULES

what is mature megakaryocyte?
40-100 uM
- nucleus is MULTILOBULATED with NO VISIBLE NUCLEOLI
- cytoplasm is VERY GRANULAR and ABUNDANTLY ACIDOPHILIC with present demarcation zones
fuzzy/cloud-like appearance

what is toxic granulation?
LARGE BLUE-BLACK GRANULES
what are dohle bodies?
LIGHT GRAY-BLUE OVAL NEAR CELL PERIPHERY
what are cytoplasmic vacuoles?
CLEAR, UNSTAINED CIRCULAR AREA
what are the pelger-heut anomaly characteristics?
PINCE-NEZ (looks like spectacles) → hyposegmentation where neutrophil nucleoli either has two lobes in a dumbbell shape or has no lobes
what is hypersegmentation?
LARGER THAN NORMAL NEUTROPHILS WITH 6 OR MORE NUCLEAR SEGMENTS
what is a pyknotic nucleus?
DEGENERATED NUCLEI → nuclear chromatin is broken down and the LOBES LOOKS SMOOTH and WILL BE SUPER DARK
what are the characteristics of the alder-reilly anomaly?
DENSE AZUROPHILIC GRANULES in ALL WBCs due to an abnormal mucopolysaccharide storage and will have a HALO EFFECT
what are the characteristics of chediak-higashi syndrome?
LARGE, COARSE AZUROPHILIC GRANULES (can resemble the granules seen in toxic granulation) and will have LARGE REDDISH BLUE IRREGULAR APPEARING INCLUSION BODIES → will also have an area of sparseness (scattered)
what are the characteristics of may-hegglin?
PERMANENT, DOHLE-LIKE CYTOPLASMIC INCLUSIONS in the granulocytes and in monocytes and will have GIANT PLATELETS (and thrombocytopenia) accompanied with them

what are dutcher bodies?
intracytoplasmic spherical inclusions → invaginates into or overlie the nucleus

what are russell bodies?
intracytoplasmic spherical inclusions → seen clearly WITHIN THE CYTOPLASM
what anemia is this?
iron - deficiency anemia
what anemia is this?
sideroblastic anemia
what anemia is this? what is the inclusion present?
sickle cell disease; howell-jolly

what hemoglobinopathy is this?
hemoglobin C disease
what hemoglobinopathy is this?
HB SC disease
what hemoglobinopathy is this?
beta thalassemia
what hemoglobinopathy is this? what inclusion is present?
thalassemia minor; basophilic stippling

what anemia is this?
pernicious anemia/b12 deficiency

what cell is this?
flame cell
what cell is this?
plasma cell
what cell is this?
hairy cell

what cell is this?
histiocyte

what cell is this?
macrophage
what cell is this?
mott cell

what cell is this?
mast cell

what cell is this?
mesothelial cell